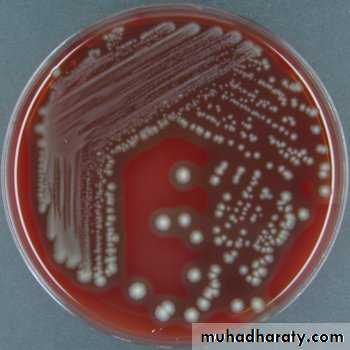
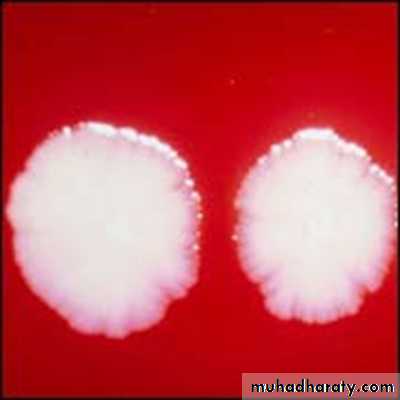

Fusobacteria, Leptotrichiaand spirochaetes
Dr. SalwaFeb.2014
Fusobacteria
Are non-sporing, anaerobic, non-motile, non- or weakly fermentative, spindle-shaped bacilli (with fused ends: hence the name).They are normal inhabitants of the oral cavity, colon and female genital tract and are sometimes isolated from pulmonary and pelvic abscesses.
species
Fusobacterium nucleatum (the type species),F periodontium and F simiae are isolated mainly from periodontal disease sites, and others such as F aloct's and F sulci are sometimes found in the healthy gingival sulcus.
Non-oral species include F gonidiajormans, F russii and F ulcerans
Characteristics
Gram-negative, strictly anaerobic, cigar-shaped bacilli with pointed ends. Cells often have a central swelling.Isolation: A Gram-stained smear of deep gingival debris obtained from a lesion of acute ulcerative gingivitis is a simple method of demonstrating the characteristic fusobacteria, together with spirochaetes and polymorphonuclear leukocytes These together with the clinical picture confirm a clinical diagnosis of acute ulcerative gingivitis.
Fusobacterium nucleatum
Culture and identification
Grows on blood agar as dull, granular colonies with an irregular, rhizoid edge.Biochemical reactions and the acidic end-products of carbohydrate metabolism help identification.
As fusobacteria can remove sulphur from cysteine and methionine to produce odoriferous hydrogen sulphide and methylmercaptan, they are thought to be associated with halitosis.
Virulence factors
• Endotoxin activity (LPS)• Hemagglutination
• Co-aggregation
Pathogenicity
The endotoxin of the organism appears to be involved in the pathogenesis of periodontal disease..Fusobacterium nucleatum is usually isolated from polymicrobial infections; it is rarely the sole pathogen. Thus, in combination with oral spirochaetes (Treponema vincentii and others
the classic fusospirochaetal infections are:
acute (necrotizing) ulcerative gingivitis or trench mouth, acute ulcerative gingivitis with resultant gross tissue loss of the facial region.
ulcerative tonsillitis causing tissue necrosis, often due to extension of acute ulcerative gingivitis
As fusobacteria coaggregate with most other oral bacteria they are believed to be important bridging organisms between early and late colonizers during plaque formation.
Antibiotic sensitivity and prevention
Fusobacteria are uniformly sensitive to penicillin, and being strict anaerobes are sensitive to metronidazole.Regular oral hygiene and antiseptic mouthwashes are the key to prevention of oral fusobacterial infections in susceptible individuals
LEPTOTRICHIA
Leptotrichia spp. are oral commensals belong to the genus Fusobacterium.They are Gram-negative, strictly anaerobic, slender, filamentous bacilli, usually with one pointed end.
L. buccalis, present in low proportions in dental plaque, is the sole representative of this genus.
SPIROCHAETES
• • Treponema causes syphilis, bejel, yaws, pinta and, in the oral cavity, acute necrotizing ulcerative gingivitis (together with fusobacteria)• • Borrelia causes relapsing fever and Lyme disease
• • Leptospira causes leptospirosis.
Lyme disease bacteria
Spirochaetes are helical organisms with a central protoplasmic cylinder surrounded by a cytoplasmic membrane.
The cell wall is similar to Gram-negative bacteria but stains poorly with the Gram stain. Underneath the cell wall run three to five axial filaments which are fixed to the extremities of the organism. Contractions of these filaments distort the bacterial cell body to give it its helical shape.
The organism moves either by rotation along the long axis or by flexion of cells. Because of their weak refractile nature, dark-ground microscopy is used to visualize these organisms in the laboratory,
although immunofluorescence is more useful for identification purposes.
All spirochaetes are strictly anaerobic or microaerophilic.
TREPONEMA
The coils of Treponema are regular, with a longer wavelength than that of leptospires .A number of species and subspecies are recognized, some of which are important systemic pathogens, while others are oral inhabitants implicated in periodontal disease.
Treponema pallidum
Habitat and transmissionLesions of primary and secondary syphilis.
Transmission
Is by direct contact with lesions, body secretions, blood, semen and saliva, usually during sexual contact; and from mother to fetus by placental transfer.
Characteristics
Slender, corkscrew-shaped 6-14 x 0.2 µm; also slender to visualize by light microscopy but can be seen by silver impregnation or immunofluorescent techniques;strictly anaerobic and extremely sensitive to drying and heat, hence dies rapidly outside the body.
Culture and identification
Cannot be cultured in vitro, but can be propagated in the testes of rabbits; T. pallidum thus harvested can be used as antigens to detect specific antibody in the patient's serum.Dark-ground microscopy of tissue fluid from primary and secondary clinical lesions helps identification
serological tests are the mainstay of diagnosis Borrelia. Treponema.and Leptospira
Pathogenicity
Causes syphilis, a sexually transmitted disease with variable manifestations. The virulence factors of T. pallidum are not well characterized.
Immunopathology plays a significant role in disease signs, especially in the late (tertiary and quaternary) stages of the disease
Antibiotic sensitivity and control
Penicillin is the drug of choice; for allergic patients tetracycline is an alternative.Prevention of syphilis is based on early detection, contact tracing and serological testing of pregnant women.
Oral treponemes
All oral spirochaetes are classified in the genus Treponema.Although many species have been described, only four have been cultivated and maintained reliably: T. denticola, T. vincentii, T. socranskii and T. pectinovarum.
In another classification they are categorized according to cell size as small, medium and large spirochaetes.
Habitat and transmission
Predominantly the oral cavity of humans and primates, at the gingival margin and crevice in particular. Transmission routes are unknown. Infections are endogenous.Characteristics
Motile, helical rods, 5-15 X 0.5 l..1m, with irregular (three to eight) spirals which are less tightly coiled than, for instance, T. pallidum.Cell walls are Gram-negative but stain poorly. The size is variable, and can be used as a basis for classification (large, medium or small).
Culture and identification
In contrast to T. pallidum, ORAL SPIROCHAETES can be grown in vitro. They are strict anaerobes, oral treponema isolation (OTI) medium. Subspecies can be differentiated by fermentation reactions and serology (agglutination).Suspect lesions of acute necrotizing ulcerative gingivitis or advanced periodontitis can be examined by obtaining a Gram stained smear of deep gingival plaque and visualizing the characteristic fusospirochaetal complex under light microscopy alternatively, dark-ground microscopy may be used.
Pathogenicity
These organisms are a component of the fusospirochaetal complex of acute necrotizing ulcerative gingivitis and Vincent's angina, and are a coagent of advanced periodontal disease.
The ability to travel through viscous environments enables oral spirochaetes to migrate within the gingival crevicular fluid and to penetrate sulcular epithelial linings as well as gingival connective tissue.
Virulence factors are little known; endotoxin is possibly contributory to disease. Treponema denticola is more proteolytic than other species and degrades collagen and dentine
Antibiotic sensitivity and control
Sensitive to penicillin and metronidazole.Prevention of infection is achieved by good oral hygiene practices.
BORRELIA (Borrelia burgdorferi)Characteristics
This species is a helical spirochaete, 0.18-0.25 X 4.3 µm. Gram-negative, it grows under microaerophilic conditions at 34°C.
Identification is by serology and immunofluorescence or enzyme-linked immunosorbent assay (ELISA).
Pathogenicity
The agent of Lyme disease, a generalized infection with neurological and cardiac manifestations and arthritis. One of the earliest and most common neurological manifestations is unilateral facial palsy.Antibiotic sensitivity
Sensitive to tetracycline and amoxicillin.